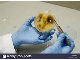
ازمایشگاه  تشخیص افات و بیماری های گیاهی

ازمایشگاه انالیز کود شیمیایی و ثبت کودی
این ازمایشگاه مورد تایید موسسه تحقیقات خاک و اب کشور جهت انالیز کودهای شیمیایی و کود های الی و بهساز خاک می باشد
اطلاعات تامین کننده
خاک بهین آزما
تهران، شهریارخدمات
آزمایش خاک، آزمایش کود شیمیایی، ازمایشگاه گیاه پزشکی، آزمایشگاه فیزیو لوزی گیاهی، آزمایشگاه اب و پساب، ازمایشگاه قرنطینه گیاه پزشکی، شیمی معدنی، خو.راک دام وطیور و ابزیان، ازمایشگاه کمپوست ، ازمایشگاه ورمی کمپوست، ازمایشگاه ثبت کودی، آزمایش خاکشناسی
مشاهده سایت فروشندهخرید از تامین کنندگان برتر پارس سنتر!

تامین کنندگان برتر پارس سنتر سرعت پاسخگویی بالاتر و محصولات بروز تری نسبت به سایر تامین کنندگان دارند.
مشخصات
- ازمایشگاه کود شیمیای
- ثبت کودی
توضیحات خدمت
در این ازمایشگاه کلیه انالیزهای کود های شیمیایی از جمله کلیه عناصر فلزی معدنی در فرمتهای محلول و کل و قابل جذب و کلاته و ازت کل و ازت نیتراته و ازت امونیومی و ازت الی و فسفر در تمام فرمها و پتاسیم و کلیه فلزات سنگین و اسید هیومیک و اسید فولویک و اسید امینه و اهن اورتو اورتو انجام میشود